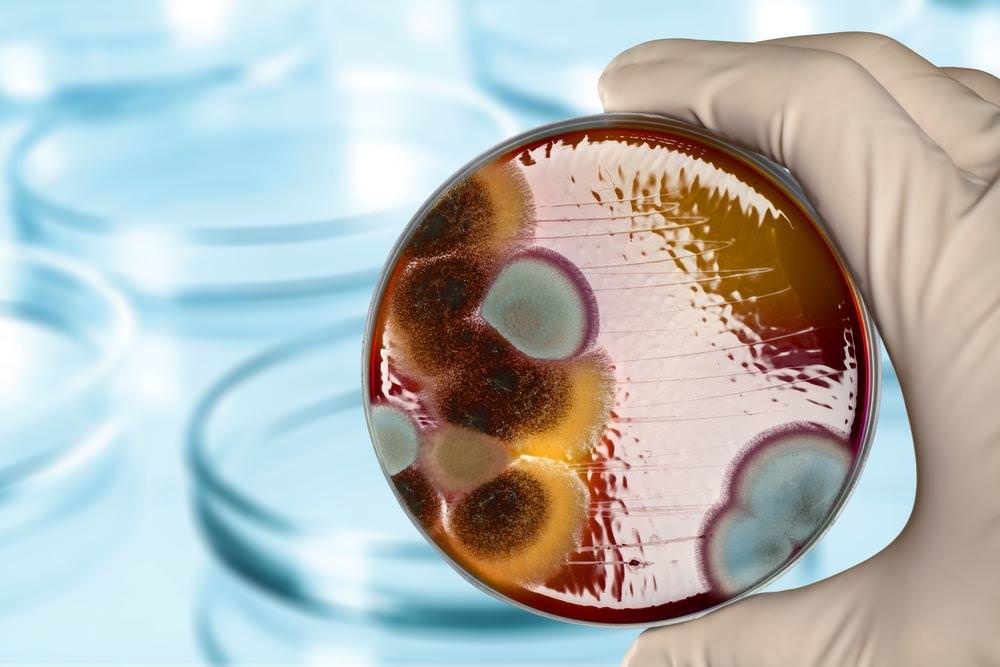

Как воспитывать гиперактивного ребенка синдром дефицита внимания СДВГ
Факторы, способствующие возникновению симптомов СДВГ
Прежде, чем было признано, что отправной точкой развития СДВГ является генетика, многие пытались усматривать причины в других факторах. В настоящее время известно, что в этих подходах была своя доля истины.
Было показано, что факторы, которые перестали рассматриваться как главная причина СДВГ, могут в существенной степени способствовать появлению симптомов или их усиливать. Важную роль в этом процессе имеет действие окружения ребенка.
В первую очередь, следует обратить внимание на отношения между членами семьи. Частые недоразумения, ссоры, крики и бурные реакции могут в значительной степени усиливать симптомы недомогания у ребенка
Очень важно также, в каких условиях ребенок воспитывается. В случае сложной семейной ситуации, ребенок развивается в атмосфере отсутствия норм и правил, в результате чего можно ожидать, что симптомы будут более четкими, а ребенка более обременителен для окружения
В развитии и усилении симптомов подчеркивается также роль экологических факторов. Осложнения во время беременности, употребление алкоголя, воздействие токсичных веществ через пищу, курение в период внутриутробной жизни ребенка могут быть связаны с более высокой восприимчивостью к заболеванию. Психомоторная гиперактивность является одним из симптомов алкогольного синдрома плода (англ. FAS – Fetal Alcohol Syndrome), к которому приводит употребление матерью алкоголя во время беременности.
Подчеркивается также роль перинатальной гипоксии. Возникающие в результате таких осложнений микротравмы мозга у ребенка могут быть причиной появления симптомов, характерных для нарушения поведения. Но это относится только к небольшой группе маленьких пациентов.
Важное значение в процессе развития симптомов СДВГ, безусловно, имеют психосоциальные факторы, такие, как частая смены места жительства и проблемы в школе, которые мешают ребенку с СДВГ общению в группе сверстников
Возникает «порочный круг» – ребёнок с СДВГ встречает с отказ со стороны окружения, что только усугублять симптомы, и в результате ведет к еще более четкому отторжению ребенка средой, в которой он живет
Важно обратить внимание на ситуацию в школе, так как соответствующая подготовка к близости с другими учениками, может свести к минимуму трудности, связанные с функционированием в обществе
Кроме того, среди причин обострения симптомов СДВГ называют расстройства, которые могут усилить дисбаланс
Обращают на себя внимание такие факторы, как астма, диета, а также аллергия. Нужно, однако, помнить, что эти факторы не вызывают СДВГ, а только могут усиливать симптомы болезни
СДВГ и влияние пестицидов
Причины СДВГ не до конца известны. Известно, что в развитии заболевания большую роль играют гены, а также алкоголь, никотин и контакт со свинцом.
Недавние исследования показывают, что пестициды, присутствующие в некоторых фруктах и овощах, также могут увеличить риск развития СДВГ. Пестициды, и, в частности органофосфатам, в больших концентрациях можно найти в ягодах и сельдерее – конечно, только в тех, которые выращивают в промышленном масштабе и с применением средств защиты растений.
Испытания прошли 1100 детей в возрасте от 8 до 15 лет. Долгосрочные воздействие на них большого количества пестицидов вызывало у них повышение риска развития СДВГ. Уровень пестицидов в организме измерялся через мочу. Не выявлено, однако, чтобы само действие пестицидов могло быть причиной возникновения СДВГ.
По словам ученых, осуществляющих исследования, пестициды могут блокировать фермент под названием ацетилхолинэстераза, работающий в нервной системе, и нарушают работу медиаторов мозга. Однако, чтобы получить уверенность в том, что касается пестицидов и их роли в развитии симптомов, необходимы дальнейшие научные исследования.
Несколько советов, которые помогут держать под контролем ситуацию
- Во время урока устраивайте небольшие физкультурные паузы. Это пойдет на пользу не только гиперактивным, но и здоровым детям.
- Классы должны быть оборудованы функционально, но без отвлекающего декора, в виде поделок, стендов или картин.
- Чтобы лучше контролировать такого ребенка, его лучше посадить на первую или вторую парту.
- Займите активных детей поручениями. Попросите их протереть доску, раздать или собрать тетрадки.
- Чтобы материал усваивался лучше, преподносите его в игровой форме.
- Творческий подход результативен в обучении всех без исключения детей.
- Разбивайте задания на небольшие блоки, так детям с СВДГ будет проще ориентироваться.
- Позвольте детям с поведенческими проблемами проявить себя в чем-то нужном, показать себя с лучшей стороны.
- Помогайте такому ученику наладить контакт с одноклассниками, занять место в коллективе.
- Зарядку во время урока можно провести не только стоя, но и сидя. Для этой цели хорошо подойдут пальчиковые игры.
- Необходим постоянный индивидуальный контакт. Нужно помнить, что они лучше реагируют на похвалу, именно с помощью позитивных эмоций закрепляются необходимые положительные модели поведения.
Заключение
Родителям, в семье которых растет гиперактивный ребенок, не стоит отмахиваться от советов врачей и психологов. Даже если со временем проблема станет менее острой, диагноз СДВГ скажется в будущем. В зрелом возрасте он станет причиной плохой памяти, неумения контролировать собственную жизнь. Кроме этого, больные с подобным диагнозом склонны к разного рода зависимостям и депрессиям. Родители должны стать примером для своего чада, помочь ему найти место в жизни, обрести веру в свои силы.
Причины патологии
Из-за чего возникает синдром, установить до сих пор не удалось. Но ученые уверены, что причиной болезни может стать совокупность нескольких факторов, которые нарушают работу нервной системы. Среди них те, которые нарушают формирование нервной системы у зарождающегося плода, что приводит к его кислородному голоданию и даже к кровоизлияниям в ткань мозга, а именно:
— загрязненность окружающей среды, для которой характерна высокая концентрация вредных веществ в воде, в продуктах питания и в воздухе;- прием лекарственных препаратов беременной женщиной;- воздействие на плод никотина, наркотиков и алкоголя;- инфекции, которые мать перенесла во время беременности;- иммунологическая несовместимость, вызванная конфликтом резус-факторов;- угроза выкидыша;- стремительные или осложненные роды, которые привели к травмированию позвоночника или головы новорожденного;- обвитие пуповиной.
Причиной возникновения СДВГ могут также стать и некоторые факторы, негативно влияющие на работу мозгла младенца. Среди них:
— болезни, во время которых температура тела ребенка поднималась выше 39 или 40 градусов;- применение определенных лекарственных препаратов с нейротоксическим действием;- тяжелые почечные патологии;- пневмония и бронхиальная астма;- порок сердца и сердечная недостаточность.
Кроме этого, существует теория о возникновении СДВГ из-за генетических факторов. Согласно данному предположению 80 % случаев патологии связано с изменениями в гене, регулирующем производство дофамина и активность дофаминовых рецепторов. В результате этого происходит нарушение в передаче биоэлектрических импульсов между клеточками мозга. При этом болезнь проявляется не только при имеющихся генетических отклонениях, а в их совокупности с неблагоприятными факторами окружающей среды. Неврологи полагают, что именно это негативное влияние способно повреждать ограниченные участки мозга. В связи с этим несогласованно и с опозданием развиваются некоторые психические функции, в том числе волевой контроль, производимый над эмоциями и импульсами. Подобная теория подтверждается тем фактом, что дети с СДВГ имели нарушения биоэлектрической активности и обменных процессов в передних мозговых зонах лобных долей, что подтвердили проводимые исследования.
Упражнения для детей с СДВГ
Некоторые упражнения и тесты весьма эффективно справляются с возбужденным состоянием.
- Сбросить напряжение. Сидя в кругу или друг напротив друга, нужно как можно быстрее передавать шарик, мягкую игрушку или любой другой предмет, не роняя его. Со временем можно увеличить скорость или правила.
- Сконцентрироваться. Несколько предметов, различных на ощупь, кладутся перед игроком, их можно потрогать. Затем малыш оголяет руку или ногу, а взрослый ласково гладит любой из вещей. Задача — угадать, какой предмет использовался.
- Планировать действия. Пусть ребенок научит маму или папу делать что-то, что он умеет. Например, варить кашу. Если он говорит, что для каши нужна мыльная вода и песок — сделайте, как он просит, а потом накормите блюдом кукол. В процессе объяснения формируется навык планирования и ответственности.
Проблемы определения
Это нарушение деятельности головного мозга впервые было замечено в 1845 году психиатром из Германии. На протяжении более ста лет ученые не могли дать полное определение заболеванию. И лишь в 1994 году ему присвоили термин. В России СДВГ стали углубленно изучать лишь десять лет тому назад.
Бывают случаи, когда диагноз дефицита внимания у ребенка заменяет психическая отсталость или психопатия. Самая страшная ошибка, когда ставят шизофрению. Чтобы правильно определить результат, родителям и врачам следует очень внимательно изучить симптоматику.
Ошибаются в этом не только врачи, но и окружающие, списывая болезнь на отсутствие должного воспитания и темперамент малыша. Ошибочно мнение в отсталости ребенка. Напротив, такие дети обладают высоким интеллектом. Синдром гиперактивности не страшен для социальной среды, но он может привести к плохим последствиям во взрослой жизни человека.
Такого малыша называют непоседой и ждут, когда с возрастом он повзрослеет и станет спокойнее. Однако с диагнозом СДВГ такого не происходит. Симптом усиливается в школьные годы, когда в привычном укладе жизни появляются новые обязанности.
Лечение недуга
Для коррекции дефицита внимания у детей необходим комплексный подход, включающий искоренение нейропсихологических и поведенческих проблем. Учитывая особенности и тип СДВГ ребёнка, подбирается личная программа реабилитации. При своевременном обращении к специалисту и проведении лечения возможно уменьшение симптомов СДВГ вплоть до выздоровления.
Медикаментозная терапия
Необходимо отметить, что назначение фармакологической коррекции приемлемо в случае, когда восстановление когнитивных функций невозможно достичь немедикаментозным лечением.
Принятие лекарственных препаратов для улучшения работы мозга у детей с дефицитом внимания — достаточно распространённая практика в США. Медикаменты делятся на несколько групп:
Психостимуляторы (Риталин (метилфенидат), Амфетамин, Дексамфетамин). Оказывают мощное стимулирующее действие на центральную нервную систему: улучшают концентрацию, снижают проявления импульсивности. В США распространено использование Риталина для лечения СДВГ, хотя нет доказательств результативности применения. Многие специалисты считают его спорным, поскольку при долгосрочном принятии Риталин приводит к развитию психозов, параноидальных и шизофренических склонностей (зрительные и слуховые галлюцинации, агрессивность), вызывает привыкание. Австралийское исследование, охватившее 2868 семей и длившееся 20 лет, показало неэффективность лечения СДВГ психостимуляторами. В ряде стран, включая Россию, метилфенидат (Риталин) запрещен.
Антидепрессанты: Имипрамин, Тиоридазин, Дезипрамин
Существенно улучшают внимание, снижают гиперактивность, но дают побочные эффекты на физическое здоровье при долгосрочном применении.
Ноотропные препараты (Ноотропил, Церебролизин, Пирацетам). Нейрометаболические стимуляторы, воздействующие на кору головного мозга и повышающие когнитивные процессы
Считаются малоопасными психофармакологическими препаратами, но могут давать осложнения. Широко используются в государствах постсоветского пространства.

Существенным недостатком медикаментозной терапии СДВГ является краткосрочность результатов лечения: состояние ребёнка улучшается только во время принятия препарата и совершенно не оказывает влияние на выздоровление. Употребление психостимуляторов подростками с дефицитом внимания развивает склонность к принятию наркотических средств.
Нефармакологическая терапия
Лечить СДВГ можно без применения лекарственных препаратов. Существуют два нелекарственных метода коррекции неврологической стороны расстройства:
- Нейропсихологический подход. Утверждает, что определённые физические упражнения влияют на работу корковых структур мозга, активизируют, наполняют энергией психические процессы. Основывается на учении А.Р. Лурии о «нейропсихологической петле развития». Данное сопровождение детей с дефицитом внимания помогает формированию самоконтроля, произвольности, повышению эффективности обучения.
- Синдромный метод. Восстановление повреждённого при родовых травмах шейного отдела позвоночника, которое нормализует кровоснабжение головного мозга.
Помимо вышеописанных методов лечения, специалисты рекомендуют:
- Занятия йогой, медитации. Помогают расслабиться, снижается импульсивность, улучшается кровоснабжение всего тела, включая головной мозг.
- Специальная диета. Исключение сахара, аллергенов, кофеина.

Коррекция поведения при СДВГ состоит из следующих методов:
Когнитивная психотерапия — самое эффективное лечение, использующееся в коррекции душевных расстройств (неврозов, фобий, депрессий). Помогает успешно социализироваться детям с дефицитом внимания, имеющим проблемы в общении со сверстниками. Импульсивность вместе с недостатком умений взаимодействовать приводит к отторжению, усугубляющему изоляцию.
Терапия включает личные и групповые занятия. Тренировки навыков общения помогают развить такие коммуникативные способности: умение строить отношения, решать конфликты, понимать других, контролировать отрицательные эмоции. Для успешного усвоения навыков необходимо посетить минимум 20 занятий группы, состоящей из 6–8 человек. Личная когнитивно-поведенческая терапия избавляет от неэффективных шаблонов действий и мышления. Помогает детям с дефицитом внимания закрепить нужное поведение.
Семейная психотерапия. Обязательно должна присутствовать при лечении СДВГ у детей. Проводится со всей семьёй. Родители встречаются со своим чувством вины за «не такого» ребёнка, учатся правильно реагировать в разыгрываемых жизненных обстоятельствах.

править СДВ и Саентолухи
Без этих шустрых парней и тут не обошлось.
В 1969 году Церковь инициировала создание Гражданской комиссии по правам человека (CCHR), которая безуспешно обвиняла психиатров США в том, что они посадили нацию на крючок разных лечебных препаратов вместо того, чтобы сажать оную на крючок саентологии. Этот чужой профит саентологам показался таким несправедливым, что от их бурной деятельности пищеварение испортилось не только, да и не столько у психологов, сколько у тех, кто возражал против СДВ на основании каких-либо научных предпосылок, а не голого фимоза, потому что трудно иметь в союзниках сумасшедших. Таким образом получилось, что количество бреда, генерируемое сторонниками СДВ, уравновесилось бредом, генерируемым хаббардистами сотоварищи, после чего в этом дурном потоке потонули уже все остальные. Короче говоря, «вор у вора украл топор», а ты, дорогой читатель, сам теперь во всем этом разбирайся.
Причины и факторы развития
Некоторые родители считают гиперактивность результатом неправильного воспитания. Однако существуют иные причины, имеющие гораздо большее влияние на внешнее поведение ребенка:
- Изменения в жизни семьи, так или иначе нарушившие привычный мир. Например, родители потеряли работу или развелись. Они могут думать, что ребенок еще слишком мал и не понимает происходящего вокруг, но на самом деле, многие дети очень чувствительны к изменениям в эмоциональном фоне в доме. Особенно сильное впечатление производит потеря члена семьи.
- Гиперактивность у детей может быть вызвана хроническими заболеваниями, частыми простудами и приемом сильнодействующих лекарств в возрасте до 1 года. Повлиять на нервную систему могут отиты и соматическое заболевание, приведшее к нарушениям функций головного мозга.
- Употребление матерью никотина или алкоголя во время беременности или грудного кормления.
- Повышение уровня свинца в организме ребенка. Вещество могло оказаться в некачественной краске, используемой для ремонта дома или для окрашивания детских игрушек.
- Травмы головы, падения в грудном возрасте.
- Пищевые добавки и острые блюда.
Болезнь может быть наследственной. Примерно в 15 случаях из 100 исследований синдрома дефицита внимания с гиперактивностью выясняется, что расстройством страдают некоторые члены семьи. Однако далеко не все дети, имеющие предрасположенность к синдрому, обязательно им болеют. Гиперактивность может не проявиться, если отсутствуют факторы для ее развития.
В дополнительную зону риска попадают те дети, у которых:
- неблагополучная обстановка дома;
- слишком строгие родители;
- нарушен режим дня;
- повышенные учебные или физические нагрузки.
К сожалению, современная система обучения часто диктует слишком высокие требования к дошкольнику. Некоторые родители считают своим долгом нанимать репетиторов с трех лет. Особенно модным стало рано учить ребенка иностранным языкам и водить сразу в несколько спортивных секций. Пытаясь воспитать маленького вундеркинда, взрослые обычно переоценивают возможности ребенка.
Другая, часто наблюдаемая крайность – это когда детей предоставляют самим себе: разрешают сидеть перед телевизором до полуночи или пропускать прием пищи.
Еще одна, распространенная причина появления синдрома гиперактивности – недостаток внимания со стороны взрослых. Ребенку кажется, что его недостаточно любят, что он никому не нужен, и подсознательно пытается протестовать.
Методы диагностики
Медицинская общественность полвека ведёт споры об эффективных способах распознавания СДВГ. Учёные канадского Университета Макмастера подтвердили, что на сегодняшний день отсутствуют специальные тесты или медицинское оборудование, напрямую диагностирующее СДВГ. К тому же критерии диагностики заболевания менялись за время существования диагноза и отличаются в разных странах.
Американские психиатры используют две шкалы: Коннорса и Йеля-Брауна, предлагающие родителям или преподавателям оценить поведение ребёнка по характерным для расстройства параметрам: невнимательность, гиперактивность и импульсивность. Однако специалисты, выступающие с критикой методов постановки диагноза, утверждают, что оценка поведения по этим шкалам слишком предвзята, а критерии диагностики настолько расплывчаты, что возможно поставить СДВГ любому здоровому ребёнку с «неудобным» поведением.
Во избежание врачебной ошибки необходима консультация нескольких специалистов, включая педиатра, психолога и детского невропатолога. Потребуются дополнительные медицинские обследования: МРТ головного мозга, допплерография, ЭЭГ, которые будут являться основой постановки психиатром диагноза СДВГ.

План поэтапного изменения проблемного поведения ребенка
Были ли вы сами неугомонным и беспокойным ребенком, которому больше нравилось бегать, чем сидеть спокойно? Нравилось ли j вам весь день мечтать? Беспокоило ли это ваших родителей? Как вы учились в школе? Принимаете ли вы лекарственные препараты, помогающие сохранять внимание? А теперь подумайте о своем ребенке. Как бы вы описали его способность сосредоточиться и выполнить задание? Каков он в сравнении со своими братьями, сестрами и другими детьми его возраста? Что больше всего беспокоит вас? Запишите то, что волнует вас больше всего
Теперь настало время действий по изменению поведения вашего ребенка. Используйте Дневник поэтапного изменения проблемного поведения ребенка для записи своих мыслей и составления плана изменений. 1. Поставьте себя на место ребенка. Представьте, что вы находитесь и классе и выполняете сложное задание, на котором вам действительно нужно сосредоточиться. Что вы чувствуете при этом? Что вы могли бы сделать для ребенка, чтобы он стал спокойнее и увереннее? Запишите план изменений. 2. Представьте ребенка, когда ему трудно сконцентрироваться на выполняемом задании. Как вы реагируете, когда он не может сосредоточиться? Помогает ли ему это выполнить задание и быть довольным собой? Есть ли что-то, что вы могли бы предпринять, чтобы дела пошли лучше? Запишите свои мысли. 3. Обратитесь к стратегии 1. Поговорите с учителем ребенка и убедитесь в том, что работа, выполняемая им в классе, соответствует его возрасту и способностям. 4. Обратитесь к стратегии 2. Организуйте специальное рабочее место для ребенка, если вы еще не сделали этого. 5. Обратитесь к стратегиям 3-5. Сначала оцените объем внимания ребенка, после чего соответствующим образом организуйте его работу. Постепенно, по мере улучшения способности ребенка к концентрации и повышения продуктивности его работы, увеличивайте время выполнения задания. 6. Обратитесь к стратегии 6. Выберите два-три подхода, применимые к ситуации с вашим ребенком. Если через несколько недель вы не заметите улучшения, проконсультируйтесь у специалиста.
Обязательства по изменению проблемного поведения ребенка
Как вы будете использовать шесть стратегий и план поэтапного изменения проблемного поведения для того, чтобы помочь своему ребенку? Запишите, что вы предпримете в течение ближайших 24 часов, чтобы начать процесс поэтапного изменения проблемного поведения ребенка.
Результаты поэтапного изменения проблемного поведения ребенка
Исправление поведения — это тяжелая, кропотливая работа, которая должна проводиться последовательно и основываться на закреплении результатов через родительское поощрение. Движение ребенка к изменениям может быть медленным, но обязательно отмечайте и поощряйте каждый его шажок на этом пути. Потребуется не меньше 21 дня, чтобы появились первые результаты, поэтому не спешите сдаваться. Помните, что если не сработает один подход, то сработает другой. Еженедельно фиксируйте прогресс в поведении ребенка, пользуясь приведенным ниже образцом. Ежедневно отмечайте успехи в Дневнике поэтапного изменения проблемного поведения ребенка.
1 неделя
2 неделя
3 неделя
Основные критерии расстройства

Диагноз СДВГ включен в классификации МКБ 10 и DSN IV.
МКБ 10 предусматривает наличие трех основных симптомов (импульсивность, дефицит внимания, гиперактивность) и устанавливает критерии заболевания, которые необходимо удовлетворить, чтобы поставить диагноз СДВГ. Код по МКБ — F 90.0
Диагностические критерии СДВГ:
- появление симптомов в младшем возрасте (обычно до 5 лет);
- подобная симптоматика наблюдается во всех кругах общения ребенка (в школе, в садике, дома, на игровой площадке или в гостях);
- исключены схожие заболевания детского возраста, которые могут вызывать подобные симптомы (аутизм, тревожное расстройство, мания, депрессия).
Невнимательность (для диагностики и постановки диагноза СДВГ у детей необходимо наличие не меньше шести признаков на протяжении 6 месяцев). Признаки невнимательности:
сложности концентрации на бытовых вещах, механические ошибки;
невозможность сконцентрировать внимание и терпеливо выслушать собеседника;
невозможность довести до конца заданную работу;
невозможность организовать любую игру;
частая потеря мелочей или других вещей;
сложность в восприятии на эмоциональном уровне интеллектуальной деятельности;
повышенное отвлечение внимания на второочередные задачи;
общая рассеянность.
Гиперактивность (необходимо наличие не меньше трех признаков на протяжении 6 месяцев):
- неспособность длительное время пребывать в спокойном состоянии;
- неусидчивость, когда это необходимо (ребенок часто подхватывается, когда необходимо оставаться на месте);
- постоянная необходимость перемещаться (бегает, прыгает), гипердинамический;
- неспособность играть в команде вместе с другими детьми в неактивные игры;
- невозможность ограничить лишнюю активность.
Импульсивность (необходимо наличие не меньше одного признака на протяжении 6 месяцев):
- преждевременный ответ на вопрос, не дослушав его до конца;
- неспособность придерживаться очереди;
- вмешательство в чужие разговоры или игры других детей;
- неспособность поддерживать тишину, даже в ситуациях, которые этого требуют.
СДВГ часто соединяется с другими нарушениями, такими, как расстройства речи, письма, чтения, счета, школьники обычно плохо учатся, невзирая на высокий интеллектуальный уровень. Часто нарушается тонкая моторика. Нередко возникают невротичные расстройства в виде энуреза, заикания. Эмоциональное развитие, как правило, не соответствует возрастной норме, дети с СДВГ эмоционально неуравновешены, взрывчатые, не могут контактировать со сверстниками, пытаются управлять ими, проявляют агрессию в случае неудач и непослушания окружающих. Отношения со взрослыми довольно сложные, полная неуправляемость детей, игнорирование запретов и социальных норм поведения ведут к агрессивным действиям со стороны взрослых.
Важно учесть, что четкой границы между нормальной и повышенной активностью ребенка нет и правильно оценить поведение поможет всесторонняя помощь родителей, близких, учителей или воспитателей детского сада. Когда их наблюдения и психологические тесты будут совпадать, следует задуматься о выставлении этого диагноза
Отклонением считается постоянное активное поведение ребенка (школьного или дошкольного возраста) во всех ситуациях, которое отличается от возрастной нормы или поведения большинства сверстников.
По DSM IV выделяют три формы этого расстройства, которые могут включать разные симптомы:
Комбинированная форма с проявлением всех трех основных симптомов.
СДВГ с нарушением внимания без гиперактивности менее заметный по своим клиническим проявлениям и реже диагностируется. Такие дети невнимательны, похожи на тихих «мечтателей» или лентяев. Они спокойны, без двигательной активности, импульсивности; кажется, что они слушают окружающих, но на самом деле их мысли заняты совсем другим
Их внимание очень сложно привлечь и легко отвлечь. Успешность у школьников обычно низкая, в целом из-за того, что родители вовремя не понимают, что нужно обратиться за медицинской помощью.
СДВГ с гиперактивностью без нарушения внимания у ребенка проявляется повышенной двигательной активностью
При этом нарушений внимания не наблюдается. Успешность у школьников либо не страдает, либо бывает пониже, чем та, которая могла бы обеспечить ребенку возможность учиться и совершать другую интеллектуальную деятельность. Однако, при всем этом сильно страдает дисциплина. Учителя будут жаловаться на поведение ребенка, постоянные импульсивные действия.
В чем минусы
«Изнутри это ощущается, как если в дождь вести машину со сломанными дворниками. Или как слушать радио, в котором одновременно транслируются все каналы», – так, например, описывают свое состояние люди с СДВГ в Сети. Потерянные или забытые где-то вещи, неоплаченные вовремя счета, хаос в доме и на рабочем столе, опоздания, несданные дела, невыполненные обещания… Плюс добавляются другого рода «взрослые» проблемы, связанные с эмоциональной неустойчивостью.

«У таких людей бывают не только резкие перепады, но и длительные периоды сниженного настроения, склонность к депрессиям», – говорит Марк Сандомирский. По словам Константина Махинова, граждане с СДВГ входят в группу риска развития различного рода зависимостей, включая алкогольную и от табака. С неврологом согласен и психотерапевт Сандомирский: «Они порой используют спиртное или другие вещества, чтобы справиться с эмоциональными трудностями. Надо иметь в виду, что это не алкоголизм или наркомания в обычном понимании, а именно попытка помочь себе». И мы уж молчим о возможных проблемах с лишним весом: усевшись на диван с большим пакетом чипсов или печенья, человек может и не заметить, как съест все до крошки, хотя вообще ничего такого не планировал.
Продолжим список – возможными трудностями в отношениях с окружающими. Так, детям обычно прощают непосредственность и эмоциональную нестабильность. Но вот малолетка выросла – и что все вокруг наблюдают? Люди с СДВГ обидчивы, конфликтны, им кажется, что их не понимают, – и порой это действительно так. Ну правда, экстравагантность поведения, неординарность мышления, перепады настроения не у всякого встречного вызовут щенячий восторг. И потом, людям вокруг невдомек, что все описанные «ужасы» поведения – это просто особенности человека, а не, грубо говоря, пофигизм и нежелание быть собранным. «Добавьте сюда непростые, по понятным причинам, отношения с самим собой – и все это приведет к проблемам с самооценкой, чаще всего – к ее занижению», – говорит Марк Сандомирский.
«Легкой» личной жизни (а точнее, поддержанию стабильных отношений) все это тоже не способствует. «Нередки «серийные браки», когда люди создают и расторгают союзы раз в несколько лет, – сообщает Марк. – Мужчины страдают от этого меньше. У женщин же самооценка падает еще сильнее. «Со мной что-то не так, я не могу создать семью», – думает дама».
А что на работе? Даже будучи хорошими специалистами, люди с СДВГ часто меняют места службы. Если отношения в коллективе не складываются, коллеги не понимают и не принимают их поведения, то женщины переживают особенно сильно – для них этот микроклимат важнее, чем для мужчин.
Медикаментозное лечение
Сегодня в США используются аналоги знаменитого риталина, запрещённого с января 2003 года к применению в США (а это страттера, концерта). В том числе из-за его наркотического действия. Страттера, концерта действительно хорошо модифицирует поведение ребёнка с СДВГ, но, надо признать, не устраняет причину гиперактивности. То есть, решает проблемы родителей и педагогов, но не ребёнка с СДВГ. Причём, к сожалению, это поведение становится более упорядоченным только на фоне действия препарата. Более того, один из поводов его запрета был выраженный «синдром отмены». Иначе говоря, когда родители по забывчивости или другим причинам пропускали время приёма риталина, ребёнок с их слов, становился «бешеным кроликом». И, все помнят серию шокирующих расстрелов в школах США. Так вот, часто это были подростки, которым бабушки, папы (мама уехала в командировку) — просто забыли дать очередную дозу риталина или его аналога. Однако, не торопитесь списывать со счетов более новые разработки в этом направлении. В ряде случаев, иному «бешеному кролику», действительно на какое-то время просто необходима фармакологическая «смирительная рубашка».
Новое поколение эффективных фармакологических модификаторов поведения при СДВГ продолжает конкурировать с новыми «не фармакологическими» разработками психофизиологов и психологов по восстановлению мозговой деятельности и коррекции причин СДВГ у детей. И это хорошо.
Юридически именно родитель несёт ответственность за своего ребёнка и делает выбор между медикаментозными методами лечения и методами психологической и психофизиологической коррекции, кстати, наиболее эффективно разработанными именно в России.
Новые разработки
Гинкго Билоба
Где на наш взгляд наиболее полезна Гинкго Билоба? При современных технологиях принятия родов в России, к сожалению, до 98% детей имеют дислокацию шейного отдела позвоночника. А через шею осуществляется кровоснабжение головного мозга. Нарушения кровоснабжения ведут к более медленному развитию мозга.
Гинкго Билоба это натуральный продукт для предотвращения органических изменений клеток головного мозга и восстановления функций центральной нервной системы. Вырабатывается из листьев реликтового дерева Ginkgo Biloba, сохранившегося со времён динозавров. В 2006 году Гинкго Билоба занял 5-е место по объёму продаж в мире среди нехимических препаратов. Не являлся лекарством до 2006 года. С 2006 года зарегистрирован в России как лекарственный препарат растительного происхождения.
Действие на организм: Гинкго Билоба нормализует мозговое и коронарное кровообращение, восстанавливает ухудшенные в результате возрастных изменений память, слух, зрение, речевые и двигательные функции, устраняет циркуляторную недостаточность (включая атеросклеротического и возрастного происхождения), восстанавливает эластичность и прочность сосудов, предотвращает тромбозы мозговых и коронарных сосудов, восстанавливает гематоэнцефалический барьер, а также ионный состав и проводимость нервных клеток, способствует нормальному обмену веществ нервных клеток и их снабжение кислородом, обеспечивает нормальную продукцию и выделение нейромедиаторов, улучшает питание сердечной мышцы, обладает антиоксидантными свойствами, помогает сохранить целостность и проницаемость клеточной стенки, помогает предотвратить бронхоконстрикцию (приступы астмы), увеличивает потенцию, оказывает успокаивающее (седативное) и антиспазматическое действие.
«Гинкго Билоба» + «Магний В6» у детей с СДВГ
Наши коллеги в Израиле получили отличные результаты у гиперактивных детей, применяя сочетание «Гинкго Билоба» + «Магний В6»
Смотрите об этом более подробно в статье «Магний В6»
. Проблема в том, что, ваша учительница в начальной школе не в курсе трудностей вашего ребёнка. Да она и не обязана быть в курсе ваших неврологических проблем. И, поэтому, ожидает от вашего ребёнка выполнения стандартных требований Минздравсоцразвития РФ.
То есть, если у вашего ребёнка диагностирован СДВГ — начните с восстановления кровообращения головного мозга. Таким образом, помогая его созреванию. Логично? Логично. Ожидая роста дерева, мы его поливаем. Для начала — мануальная терапия или массаж шейного отдела позвоночника.

Виды нейтрофилов











Лечебные мероприятия




Точный диагноз может быть поставлен больному с помощью ЭКГ.
У спортивных девушек показатель отклоняется от нормального в сторону уменьшения.

Для восстановления нормального показателя ЧСС человеку может быть назначен Аминалон.
При такой патологии можно обогатить рацион цветной капустой.
Улучшить свое состояние можно, выполняя перекаты на спине.


Для выявления причинного фактора проводится гониоскопическое исследование.

Сифилитическую форму болезни можно устранить Доксициклином.
Среди народных средств для устранения патологии можно выбрать корень алтея.

Повышенный уробилиноген делает мочу темнее
Симптомы заболеваний Подробнее » Почему моча пахнет ацетоном
Симптомы заболеваний Подробнее » О чем говорят кетоновые тела в моче при беременности


В расшифровке анализа, уровень уробилиногена обозначается знаком «+», что обозначает слабоположительную реакцию на присутствие вещества, «++» – положительную и «+++» – резкоположительную.

Чем разнообразнее питание человека, тем больше натуральных витаминов и микроэлементов он получает.




Кроверазжижающие препараты
Перед назначением любого препарата врач обязан направить пациента на кардиограмму
Сильная сердечная мышца — результат приема БКК







Тотему можно применять даже при беременности
Крапивный чай — одно из самых действенных народных средств для повышения уровня железа
Хотите повысить уровень железа — ешьте мясо
